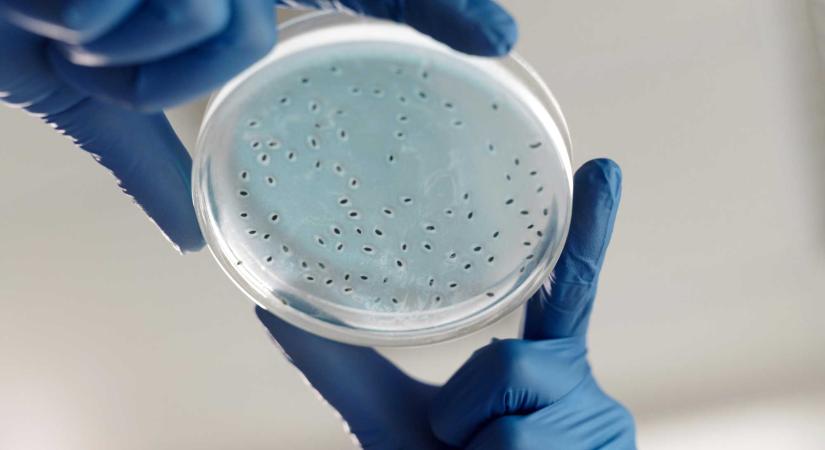
Nem vagy egyedül a testedben: így őrzik a mikrobák az egészségünket

Nem vagy egyedül a testedben: így őrzik a mikrobák az egészségünket
Mara Gyöngyvér biológussal, a Sapientia – EMTE oktatójával, a humán mikrobiom kutatójával beszélgettünk a testünket benépesítő mikrobákról, amelyek szerepéről egyre többet fedeznek fel a kutatók.
- Hirdetés -